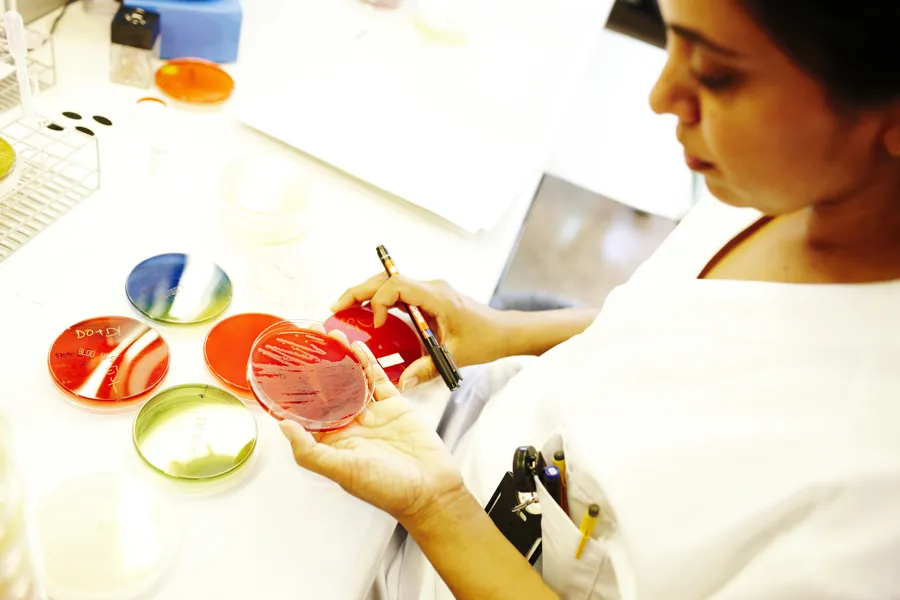

Ved Sykehuset i Vestfold drives helseforskning av høy kvalitet innen en rekke ulike fagområder. Likevel ønsker vi å øke forsknings- og innovasjonsaktiviteten ved sykehuset ytterligere de kommende årene.
Forskning og innovasjon ved SiV
Forskning er en av sykehusets kjerneoppgaver, og viktig for kvaliteten og sikkerheten i pasientbehandlingen. Sykehuset i Vestfold har mange etablerte og aktive forskningsgrupper, samt dyktige enkeltforskere som gjennomfører studier og frembringer ny kunnskap innen ulike fagområder. De siste årene har forskningsaktiviteten ved sykehuset vært økende og sykehuset deltar i ulike nasjonale og internasjonale forskningsnettverk og samarbeid.
Innovasjonsprosjekter ved SiV
Det foregår en rekke innovasjonsprosjekter ved Sykehuset i Vestfold, spesielt innen tjenesteinnovasjon og digitalisering, som fokuserer på å utvikle nye tjenester og/eller ta i bruk ny teknologi til det beste for våre pasienter, pårørende, medarbeidere og samarbeidspartnere. Det er et stort behov for å tenke nytt og skape nye produkter og tjenester i sykehuset og i samhandling med primærhelsetjenesten med utgangspunkt i brukernes behov.

Forskningshåndboken
Forskningshåndboken er utarbeidet av arbeidsgruppe under Regionalt nettverk for pasientadministrativ
kvalitetskontroll (PASK). Arbeidsgruppen deltakere har fagbakgrunn fra klinikk og forskningsmiljø, analyse
eller klinisk IKT og arbeider ved Akershus universitetssykehus HF, Oslo universitetssykehus HF, Sykehuset i
Vestfold HF, Sunnaas Sykehus og Sykehuset Østfold HF.

Sist oppdatert 02.02.2024